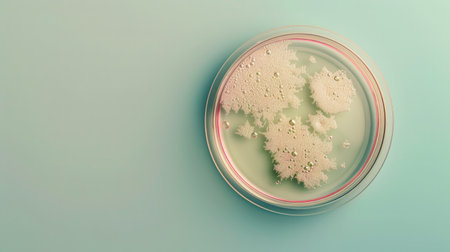
Abstract laboratory concept with Petri dishes containing glowing bacterial colonies with a pastel iridescent effect, minimalist design .の素材

素材 - Abstract laboratory concept with Petri dishes containing glowing bacterial colonies with a pastel iridescent effect, minimalist design .
作品情報
Abstract laboratory concept with Petri dishes containing glowing bacterial colonies with a pastel iridescent effect, minimalist design .
- ID:272618331
- 作品種別:
- 作者名:Tetiana Kreminska
キーワード
- Petri
- abstract
- aesthetic
- bacteria
- bacterial
- bioart
- biochemistry
- biologic
- biology
- bioluminescence
- biotech
- biotechnology
- colonies
- creative
- culture
- decoration
- design
- development
- discovery
- dishes
- effect
- engineering
- environment
- equipment
- experiment
- experimental
- futuristic
- genetic
- glowing
- growth
- innovation
- investigation
- iridescence
- iridescent
- lab
- laboratory
- microbial
- microbiology
- minimalist
- modern
- observation
- pastel
- research
- science
- scientific
- sterile
- study
- vivid
類似作品
Microbiology La...
Pouring liquid ...
Petri dish with...
Petri dish with...
Petri dish with...
Cosmetic swatch...
Mixed of bacter...
Top view of pet...
Test tubes flas...
Sparkling multi...
Microbiology La...
Antiaging cosme...
top view petri ...
Petri dishes wi...
A skin serum or...
Production line...
Test tubes flas...
Hands, plant sc...
Researchers wor...
Scientific rese...
Viruses and bac...
Petri dishes wi...
Blue spot on wh...
Researchers wor...
Top view of lab...
Abstract medica...
Production line...
Petri dish with...
Biochemical Gla...
Petri dishes wi...
Scientist Works...
Research of vir...
Laboratory glov...
Production line...
Abstract cosmet...
The hand holds ...
Organic cosmeti...
Overhead view s...
Scientist Works...
hand of scienti...
Production line...
Petri dishes wi...
Viruses and bac...
Top view of the...
Backgrounds of ...
Viruses and bac...
Petri Dish rese...
Out focus bood ...
glass microbiol...